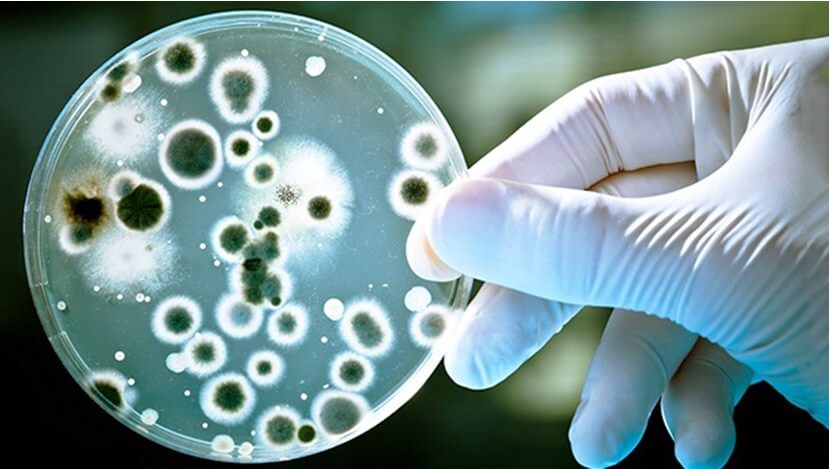

Польза и вред одноклеточных грибков

Поскольку пивные дрожжи — это не лекарственный препарат, то их чаще всего применяют как дополнительное средство при лечении различных недугов. Главное, поддержать организм при ослабленном состоянии, в период стрессов или депрессий. Это защита от авитаминоза и помощь при минеральном голодании.
Чем полезны дрожжи? Рассмотрим положительные стороны применения этого БАДа:
- Укрепление организма за счет дополнительного поступления витаминов и минералов.
- Активное увеличение мышечных волокон (прирост массы мышц) при физических тренировках. Параллельно полезно применять янтарную кислоту, способную восстановить активность мышц после физических нагрузок.
- Польза для мужчин состоит в нормальном созревании половых клеток, стабильной работе предстательной железы за счет наличия в дрожжах цинка. А сбалансированная комбинация компонентов укрепляет психику и эндокринную систему.
- Для женщин это средство продления активности и молодости. Витамины улучшают самочувствие, снимают синдром усталости и раздражения, снижают количество нервных стрессов. Половые клетки созревают вовремя, исходя из месячного цикла, уменьшается ломкость ногтей и выпадение волос, кровотечения становятся не столь обильными.
Польза пивных дрожжей выражена благодаря высокому содержанию железа, что является профилактикой анемии и восстанавливает уровень гемоглобина в крови. За счет кальция костная ткань служит намного дольше, и препарат используется в пожилом возрасте для профилактики остеопороза.

Польза и вред зависит от грамотного и продуманного приема в соответствии с инструкцией и консультацией врача. Вред дрожжи могут нанести в следующих случаях:
- при беременности и в период лактации их прием желательно ограничить или не употреблять совсем, поскольку нет данных их влияния на развивающийся плод;
- при аллергической реакции организма на препарат;
- при почечной недостаточности или подагре;
- в пожилом возрасте;
- грибки способны оказать влияние на желудочно-кишечный тракт: изменить состав кишечной микрофлоры и вызвать дисбактериоз;
- при приеме живых дрожжей можно спровоцировать развитие молочницы.
При аллергии, если потребность в препарате высока, прием нужно снизить до минимума, но лучше заменить на другое средство. Редко наблюдаются побочные эффекты, связанные с расстройством пищеварения: вздутие, диарея, отрыжка.
Противопоказаний и побочных эффектов немного, но исключать их полностью нельзя. Поэтому при различных недомоганиях или подозрениях, связанных с приемом дрожжевых грибков, обратитесь за консультацией.
Что это за БАД и каков состав?
Пивные дрожжи (Saccharomyces cerevisiae) – это одноклеточные грибки, которые традиционно применяют для варки пива и приготовления теста.
В последние годы их стали использовать не только в пищевой промышленности, но и в медицине в виде специальных добавок к пище.
Точный состав таблетки с Saccharomyces cerevisiae может немного отличаться в зависимости от производителя. Если рассматривать усреднено, то препарат содержит (в расчете на 1 таблетку):
- 58 ккал;
- 8 грамм белка;
- 3 грамма клетчатки;
- 6.5 грамм углеводов;
- по 45% суточной нормы селена и витамина В2;
- 40% витамина В1
- по 25% ниацина и меди;
- 20% витамина В6;
- 9% калия;
- 7.5% фолатов.
При этом таблетки с пивными дрожжами представляют собой пробиотики, обогащённые хромом. Этого микроэлемента в них немного. Но его и не должно быть много, так как он влияет на работу организма человека в ничтожно малых концентрациях. Особенно сильное влияние имеет на регуляцию уровня сахара в крови.
Что такое дрожжи и какими они бывают
Это одноклеточные бесхлорофилльные микроорганизмы растительного происхождения, которые запускают процессы сбраживания или окисления органических соединений, в первую очередь —, углеводов. Человек с продуктами питания потребляет несколько полезных видов дрожжей:
- винные: находятся на плодах, ягодах,
- пивные: содержатся в солоде, хмеле,
- молочные: в молочнокислых продуктах,
- хлебопекарные: находятся на различных видах злаков.
Уникальность и полезные свойства дрожжей в том, что они могут жить в отсутствии воздуха и получать энергию из процессов брожения и выделения спиртов. Благодаря прохождению воздуха через пищевой субстрат они потребляют кислород и выделяют углекислый газ. Однако, если в среде присутствует большое количество глюкозы, процесс сбраживания начинается даже без доступа воздуха.
Внимание! Брожение – это естественный природный процесс, который находится не только вне человеческого тела, но и внутри него

Как выбрать и использовать покупные дрожжи – выбор и инструкция по применению
Можно применять сушеные винные ЧКД, которые переносят высокие или низкие температуры, производят обильную пену или наоборот мало пены, имеют большую активность или работают медленно, в какой степени сохраняют натуральный вкус сырья и определенные характеристики и так далее. Учитывая все это, каждый сможет приготовлять вино практически любого типа в домашних условиях на купленных ЧКД. Дополнительно, возможно применение специальных дрожжей, которые лучше всего подходят к тем или иным ингредиентам (производство плодово-ягодных, игристых вин, сакэ).
Перед тем как добавить винные дрожжи, инструкция по применению включает следующее: их необходимо повторно гидратировать в «культуре закваски»: процесс тщательно контролируется относительно температурных условий, гарантируя, что дрожжевые клетки не погибнут вследствие «холодного шока». Проще говоря, метод заключается в том, что ЧКД вводят в жидкую среду, благоприятную для быстрой активации и размножения, лучше в тот же день, до добавления в сусло. Жидкость с активированной культурой затем добавляется в сусло, где дрожжевая культура очень быстро размножается до необходимой плотности.
- Такое действие приводит к быстрому брожению: ароматы и другие нюансы, которые мы хотим «захватить» из сырья и придать их вину, – скоропортящиеся, быстро рассеиваются или изменяются в течение нескольких дней, если не часов. Чем раньше дрожжи их могут поглотить, тем лучше будет готовое вино.
- Добавление закваски (в отличие от использования сухих дрожжей непосредственно из пакета) сэкономит время, от одного до нескольких дней в зависимости от штамма дрожжей и размера винной партии.
- Инструкция по применению обеспечивает жизнеспособность штамма. Как правило, покупая сухой продукт, мы не представляем, сколько лет дрожжевой культуре в пакете. В пакетированных условиях она может выживать в течение долгого времени, но с учетом постоянной и приемлемой температуры!
Названия пивных дрожжей в таблетках
Эвисент. Производством этого препарата занимается . Показания к применению:
- Дефицит витаминов.
- Нарушения метаболизма.
- Неполноценный рацион.
- Перегрузки: физические и умственные.
Форма выпуска – таблетки. Их прием позволяет улучшить состояние волос, кожи и ногтей, повысить работоспособность, нормализовать работу ЖКТ. Противопоказанием к приему является непереносимость компонентов, входящих в состав.
Стоимость упаковки со 100 таблетками – 145 рублей.
Эко-мон. Эффект от приема пивных дрожжей, который обещает производитель:
- Нормализация работы ЖКТ.
- Очищение кишечника.
- Повышение естественной сопротивляемости организма.
- Избавление от усталости.
- Нормализация работы мускулатуры.
- Восполнение дефицита веса.
Чтобы получить от препарата максимум пользы, необходимо изменить свой рацион в сторону увеличения калорийности, а также начать заниматься спортом. К побочным эффектам от проводимой терапии относят метеоризм. После завершения лечения этот симптом проходит.
Производится препарат в России. Стоимость упаковки – 120 рублей.
Биотерра. Главным преимуществом этого препарата является то, что он содержит серу, и помогает быстро избавиться от акне и угревой сыпи. Люди, принимавшие пивные дрожжи Биотерра отмечают, что эффект развивается уже через 14 дней.
В качестве основного недостатка называют необходимость приема сразу 15 таблеток. Пьют суточную дозу один раз в день, за 10 минут до еды. К менее значимым минусам относят неприятный запах таблеток. В качестве основного побочного эффекта называют усиленное вздутие живота. Люди отмечают, что во время терапии у них повысился аппетит и произошел набор веса.
Производится препарат в Белоруссии. Его стоимость – 60 рублей.
Нагипол 100. В состав входят витамины группы В, витамин F и H, аминокислоты, белки, липиды, ферменты, нуклеотиды, микроэлементы. Эффекты, которые можно достичь благодаря приему Нагипол 100:
- Повысить вес.
- Простимулировать иммунитет.
- Быстрее восстановиться после перенесенной операции.
- Вывести шлаки и тяжелые металлы.
- Помочь организму справиться с респираторными заболеваниями.
Не следует принимать препарат при индивидуальной непереносимости компонентов, входящих в состав.
Стоимость упаковки – 100 рублей (оптовая – 85 рублей).
Натурливит (naturlivit). Препарат содержит пивные дрожжи и витамины В1 и В6. Эффекты, которых удается достичь:
- Повысить иммунитет.
- Укрепить здоровье.
- Нормализовать работу системы пищеварения.
- Стабилизировать метаболизм.
- Повысить массу тела.
Не следует принимать препарат при аллергии на компоненты, входящие в его состав.
Цена упаковки – 150 рублей (оптовая – 128 рублей).
Экко Плюс. Дрожжи обогащены фолиевой кислотой, цистеином, витаминами группы В, биотином. Их прием позволяет нормализовать метаболизм, скорректировать вес, справиться с кожными высыпаниями.
Не рекомендуется использовать дрожжи женщинам в положении, а также кормящим матерям.
Стоимость препарата – 127 рублей (оптовая цена – 105 рублей).
Дрожжи: польза для волос и кожи
Как только человек начинает употреблять назначенные врачом дрожжи, его кожные покровы, волосы и ногти сразу это отражают. Восстанавливается эластичность кожи, волосы и ногти становятся крепче, быстрее растут.
Как наружное применение дрожжей, так и употребление их внутрь, помогает справиться с:
• дерматитом;
• акне;
• экземами;
• ожогами;
• себореей;
• перхотью.
Для питания и улучшения внешнего вида кожи можно применять следующие маски:
• смешать чайную ложку меда с 20 граммами дрожжей, добавить столовую ложку ржаной муки, залить четырьмя столовыми ложками теплого молока;
• кефир смешать с 20 граммами дрожжей, маска должна иметь консистенцию густой сметаны.
Дрожжевые маски для кожи лица наносят на очищенное лицо не дольше чем на 15 минут, после чего тщательно смывают теплой водой.
Чтобы укрепить волосы, на водяной бане растворить полпачки дрожжей с чайной ложкой сахара. Оставить до начала брожения. Добавить по чайной ложке горчицы и меда. Нанести на корни волос, распределить по всей длине и накрыть целлофановым пакетом или шапочкой. Поверх укутать полотенцем и оставить на час-полтора. Хорошенько промыть волосы водой.
Врачи рекомендуют сочетать наружные процедуры и прием дрожжей внутрь. Курс лечения дрожжами может достигать трех месяцев
Сколько дрожжей нужно организму в день
Дрожжи в качестве полезного лечебного средства назначают при многих заболеваниях. Это различные инфекции, фурункулез, сахарный диабет, болезни кожи, патологии ЖКТ. Во всех этих случаях количество препарата должно быть установлено лечащим врачом. Например, при низкой кислотности рекомендуется выпивать за полчаса до еды по 100 мл пивной закваски в течение месяца.
В профилактических целях для усиления белкового и витаминного питания рекомендуется следующее количество дрожжей в сутки:
- сухие – до 25 г;
- прессованные – до 100 г;
- дрожжевая паста – до 50 г;
- питьевые – до 500 г.
Рекомендуем к прочтению: Полезен ли хлеб из тостера
Польза питьевых дрожжей была широко известна во время войны. С их помощью спасали советских людей от голода и болезней, помогали выживанию. Дрожжи изготавливали из пшеничной или ржаной муки: это был высокопитательный и приятный на вкус напиток.
Виды пивных дрожжей
Приобрести дрожжи можно в нескольких видах, и каждая из форм обладает своими свойствами и особенностями.
- Жидкие, или живые, дрожжи. Такой продукт реализуется пивзаводами, и по пользе он превосходит все основные разновидности. Однако у добавки есть минус — она недолго хранится, к тому же при дисбактериозе, кандидозе и других грибковых заболеваниях ее пить нельзя — свойства принесут вред.
- Порошок. Такую полезную добавку можно купить в аптеке. Удобна она тем, что ее можно хранить даже в комнатном тепле и довольно долго. Перед употреблением порошок разводят водой.
- Таблетки. Дрожжевая пищевая добавка пользуется наибольшей популярностью, поскольку хранится долго, а принимать ее легко — не нужно отмерять дозировку и предварительно готовить продукт к использованию. Кроме того, именно таблетки могут включать в себя полезные дополнительные элементы.
Свойства дрожжей сухих
Пищевая ценность и состав | Витамины | Минеральные вещества
Сколько стоит дрожжи сухие ( средняя цена за 1 упак.)?
Москва и Московская обл.
15 р.
Одноклеточные микроорганизмы, которые отличаются растительным происхождением, это и есть дрожжи. Их основное свойство — способствовать процессам брожения. Для ферментации и выпечки человек начал использовать дрожжи несколько десятков столетий назад. Кстати, слово дрожжи характеризуется праславянскими истоками — происходит оно от глагола, который означает давить или месить.
Не так давно дрожжи можно было приобрести в единственном варианте – в форме, представленной прессованными брикетами. У такого продута были свои достоинства: в частности, свежие дрожжи были в полной боевой готовности. Однако минусы у них тоже были – в связи с высоким содержанием влаги прессованные дрожжи не могли долго храниться.
Для решения вечной проблемы пищевых продуктов, которая касается увеличения срока их хранения, дрожжи начали сушить, тем самым способствуя их переходу из активного состояния в спящее. Зато такой подход в значительной степени продлил срок хранения сухих дрожжей – от двенадцати суток до практически двух лет.
Теперь потребителям, которые могут приобрести сухие дрожжи в магазине, не обязательно делать это в канун выпечки – их можно купить про запас. Кроме того, для магазинов сухие дрожжи во многом более выгодны, чем прессованные – им не требуется специальных условий хранения и они занимают немного места.
Зачастую необходимо заменить прессованные дрожжи сухими, для чего существует специальное соотношение этих продуктов. Как правило, 50 граммов свежих заменяет один пакетик сухих дрожжей (около 10-11 граммов). Калорийность сухих дрожжей составляет около 325 ккал на 100 граммов.
Что такое пивные дрожжи и для чего их принимают
По сути, пивные дрожжи являются дрожжевыми грибками или простейшими одноклеточными организмами, отвечающими за процесс брожения. Применяют их в изготовлении пива, именно они придают алкогольному напитку крепость и приятный горький вкус.
Но пивные грибки используются не только в пивной промышленности. В аптеках их продают как пищевую добавку, поскольку их свойства очень полезны для здоровья. В них содержится масса витаминов и минералов, и эффект пивных дрожжей оказывается благотворным для всех систем организма.
Чтобы пивные грибки в таблетках принесли пользу и не причинили случайного вреда, применять их нужно по схеме, указанной в инструкциях.
- Дневная дозировка для детей от 3 до 12 лет составляет не больше 3 таблеток в сутки — по таблетке на полный желудок.
- Подросткам и взрослым необходимо также принимать добавку трижды в день, но по 2 таблетки.
После этого нужно сделать интервал между курсами, чтобы переизбыток полезных веществ не нанес вреда.
БАДы назначают для улучшения общего состояния организма, но разные составляющие действуют на обменные процессы индивидуально.
Что касается пивных дрожжей, то их назначают в следующих случаях:
- при заболеваниях кожных покровов, крови и нехватки минеральных веществ;
- для стимуляции работы желудка и кишечника, особенно пивные дрожжи показаны при гастрите с пониженной кислотностью;
- при заболеваниях опорно-двигательного аппарата;
- препарат показан к применению при косметологических проблемах;
- назначают для роста волос и ногтей;
- пивные дрожжи пьют при обострении хронических болезней, как общеукрепляющее средство;
- при нарушениях в работе нервной системы, так как витамин В, входящий в состав препарата способствует восстановлению сил и уменьшению невралгических болей;
- пи частых простудах назначают пивные дрожжи для поддержания иммунной системы;
- назначают беременным женщинам, так как БАД способствует развитию плаценты и нормализации работы яичников;
- назначают при нарушении сна и подавленном состоянии;
- при хронической усталости и периодических депрессиях;
- при нарушении работы эндокринной системы;
- назначают в постоперационный период для улучшения состояния организма, быстрого восстановления сил.
Чтобы понять необходимость применения пивных дрожжей, рассмотрим, какую пользу они приносят организму человека:
- помогают тучным людям похудеть, улучшая метаболизм и работу ЖКТ;
- укрепляют иммунную систему;
- помогают человеку справиться со стрессовыми ситуациями и депрессиями;
- выводят токсины и свободные радикалы из организма;
- улучшают мозговую деятельность, повышают настроение и работоспособность;
- понижают «вредный» холестерин и регулируют уровень сахара при диабете;
- повышают аппетит и улучшают работу всех систем организма человека;
- помогают клеткам обновляться;
- благодаря большому количеству витаминов помогают организму сохранять энергию;
- способствуют регенерации тканей, при этом язвы и раны быстро затягиваются;
- повышают общий тонус организма;
- стимулирует работу поджелудочной железы, что способствует выработке инсулина;
- лечит угревую и себорейную сыпь на лице и теле;
- восстанавливает силы при изнурительных тренировках, или тяжелой работе;
- замедляет процесс старения всех органов;
- улучшает самочувствие;
- способствует оздоровлению волос и росту ногтей.
Все кто прошел курс лечения пивными дрожжами, отмечают значительное улучшение состояния здоровья и общего самочувствия.
Но не стоит заниматься самолечением, только врач может определить курс лечения и дозировку.
Не стоит думать, что препарат абсолютно безвреден, так как применение ненатуральных препаратов может усугубить состояния здоровья.
Дрожжи показаны при многих болезнях, иногда оказывают спасительную помощь здоровью человека. Но если нарушить баланс, организм становится уязвимым к болезнетворным бактериям.
В хлебобулочных изделиях, производимых с применением дрожжей больше вреда, чем пользы, так как живые дрожжевые микроорганизмы убиваются при выпечке, а остаются только те, которые способствуют развитию дисбактериоза, кандидоза и раковых клеток.
Если дрожжи принимать бесконтрольно, то результатом может стать образование камней в почках, запоры, газообразование, нарушения работы всех органов.
Как влияют БАДы на похудение?

У таблеток с пивными дрожжами есть сразу несколько особенностей, которые позволяют им положительно влиять на процесс нормализации веса.
Способность хрома снижать уровень сахара в крови и одновременно увеличивать чувствительность тканей к инсулину важна не только для профилактики и лечения диабета 2-го типа, но и для похудения. Так как массивный выброс инсулина, имеющий место при резком подъеме глюкозы и низкой чувствительности клеток к гормону, является одной из причин быстрого формирования лишних жировых отложений.
Растительная клетчатка добавки замедляет усвоение пищи. Это также помогает предупредить резкий подъем сахара в крови после еды и дальнейший обильный выброс инсулина.
Таблетки с Saccharomyces cerevisiae – это пробиотики. И как всякие пробиотики, положительно влияют на состав кишечной микрофлоры
Это важно для нормализации веса. Так как при наборе лишней массы тела состав флоры кишечника изменяется
И эти изменения ускоряют дальнейшее формирование жировых отложений.
Противовоспалительная и иммуномодулирующая активность БАДа дает возможность бороться с хроническими воспалительными процессами, которые всегда имеют место в организме людей с чрезмерно избыточной массой тела.
Препараты с дрожжами увеличивают выносливость. Позволяют двигаться более активно в течение всего дня. А, следовательно, сжигать ежесуточно больше калорий. На фоне их приема легче проводить интервальные тренировки высокой интенсивности, представляющие собой лучшие упражнения для похудения живота и боков.
Внимание!
Несмотря на всю пользу таблеток с пивными дрожжами для похудения, у них есть и вред для снижения веса, который связан с их высокой калорийностью. В 1 таблетке содержится 58 ккал. А если учесть, что инструкция диктует принимать от 2-до 6-ти таблеток, то становится понятно, насколько сильно такое лечение увеличивает общее количество калорий, поступающее в организм за сутки.
Поэтому если вы находитесь на диете для похудения, но при этом собираетесь принимать дрожжевые добавки, то обязательно тщательно подсчитывайте то количество калорий, которое они вам дают и затем корректируйте калорийность своего рациона питания.
В противном случае вы рискуете поправиться, а не похудеть.
Работают или нет пивные дрожжи для набора веса спортсменам?
Гипотеза о том, что препараты с Saccharomyces cerevisiae способны помочь быстро нарастить мышечную массу людям, которые об этом мечтают, довольно популярна в атлетическом мире. Во всяком случае, это одно из объяснений того, для чего принимают пивные дрожжи здоровые молодые мужчины.
Но на самом деле эта версия не имеет каких-то строгих научных подтверждений. Даже те, кто рекомендует принимать дрожжи для набора масса тела, не могут дать какого-то уникального описания их биологической активности, позволяющей наращивать мышцы. Кроме того, что это общеукрепляющий препарат, богатый белком, клетчаткой и витаминами.
И это на самом деле так. На фоне приема пивных дрожжей человек может более активно тренироваться. А, значит, демонстрировать лучшие спортивные результаты, в том числе и по набору массы тела, если он к этому стремиться.
При этом таблетки достаточно калорийны. Что в данном случае является их большим плюсом, а не минусом.
Однако никаким специфическим влиянием на рост мышечной массы они не обладают.
Также стоит иметь в виду, что мужчинам для набора веса лучше принимать пивные дрожжи, обогащенные цинком, так как они усиливают выработку тестостерона.
Калорийность Дрожжи. Химический состав и пищевая ценность.
Пищевая ценность и химический состав «Дрожжи».
В таблице приведено содержание пищевых веществ (калорийности, белков, жиров, углеводов, витаминов и минералов) на 100 грамм съедобной части.
| Нутриент | Количество | Норма** | % от нормы в 100 г | % от нормы в 100 ккал | 100% нормы |
| Калорийность | 109 кКал | 1684 кКал | 6.5% | 6% | 1545 г |
| Белки | 12.7 г | 76 г | 16.7% | 15.3% | 598 г |
| Жиры | 2.7 г | 56 г | 4.8% | 4.4% | 2074 г |
| Углеводы | 8.5 г | 219 г | 3.9% | 3.6% | 2576 г |
| Вода | 74 г | 2273 г | 3.3% | 3% | 3072 г |
| Зола | 2.1 г | ~ | |||
| Витамины | |||||
| Витамин В1, тиамин | 0.6 мг | 1.5 мг | 40% | 36.7% | 250 г |
| Витамин В2, рибофлавин | 0.68 мг | 1.8 мг | 37.8% | 34.7% | 265 г |
| Витамин В5, пантотеновая | 4.2 мг | 5 мг | 84% | 77.1% | 119 г |
| Витамин В6, пиридоксин | 0.58 мг | 2 мг | 29% | 26.6% | 345 г |
| Витамин В9, фолаты | 550 мкг | 400 мкг | 137.5% | 126.1% | 73 г |
| Витамин Е, альфа токоферол, ТЭ | 0.8 мг | 15 мг | 5.3% | 4.9% | 1875 г |
| Витамин Н, биотин | 30 мкг | 50 мкг | 60% | 55% | 167 г |
| Витамин РР, НЭ | 14.3 мг | 20 мг | 71.5% | 65.6% | 140 г |
| Ниацин | 11.4 мг | ~ | |||
| Макроэлементы | |||||
| Калий, K | 590 мг | 2500 мг | 23.6% | 21.7% | 424 г |
| Кальций, Ca | 27 мг | 1000 мг | 2.7% | 2.5% | 3704 г |
| Магний, Mg | 51 мг | 400 мг | 12.8% | 11.7% | 784 г |
| Натрий, Na | 21 мг | 1300 мг | 1.6% | 1.5% | 6190 г |
| Фосфор, Ph | 400 мг | 800 мг | 50% | 45.9% | 200 г |
| Хлор, Cl | 5 мг | 2300 мг | 0.2% | 0.2% | 46000 г |
| Микроэлементы | |||||
| Железо, Fe | 3.2 мг | 18 мг | 17.8% | 16.3% | 563 г |
| Йод, I | 4 мкг | 150 мкг | 2.7% | 2.5% | 3750 г |
| Марганец, Mn | 4.3 мг | 2 мг | 215% | 197.2% | 47 г |
| Медь, Cu | 320 мкг | 1000 мкг | 32% | 29.4% | 313 г |
| Молибден, Mo | 8 мкг | 70 мкг | 11.4% | 10.5% | 875 г |
| Цинк, Zn | 1.23 мг | 12 мг | 10.3% | 9.4% | 976 г |
| Усвояемые углеводы | |||||
| Моно- и дисахариды (сахара) | 8.5 г | max 100 г | |||
| Незаменимые аминокислоты | |||||
| Аргинин* | 0.53 г | ~ | |||
| Валин | 0.7 г | ~ | |||
| Гистидин* | 0.3 г | ~ | |||
| Изолейцин | 0.74 г | ~ | |||
| Лейцин | 0.9 г | ~ | |||
| Лизин | 0.91 г | ~ | |||
| Метионин | 0.23 г | ~ | |||
| Метионин + Цистеин | 0.35 г | ~ | |||
| Треонин | 0.64 г | ~ | |||
| Триптофан | 0.17 г | ~ | |||
| Фенилаланин | 0.5 г | ~ | |||
| Фенилаланин+Тирозин | 1.17 г | ~ | |||
| Заменимые аминокислоты | |||||
| Аланин | 0.37 г | ~ | |||
| Аспарагиновая кислота | 0.68 г | ~ | |||
| Глицин | 0.47 г | ~ | |||
| Глутаминовая кислота | 1.57 г | ~ | |||
| Пролин | 0.49 г | ~ | |||
| Серин | 0.58 г | ~ | |||
| Тирозин | 0.68 г | ~ | |||
| Цистеин | 0.12 г | ~ | |||
| Стеролы (стерины) | |||||
| Холестерин | 260 мг | max 300 мг | |||
| Насыщенные жирные кислоты | |||||
| Насыщеные жирные кислоты | 0.5 г | max 18.7 г | |||
| 12:0 Лауриновая | 0.03 г | ~ | |||
| 14:0 Миристиновая | 0.04 г | ~ | |||
| 16:0 Пальмитиновая | 0.34 г | ~ | |||
| 18:0 Стеариновая | 0.09 г | ~ | |||
| 20:0 Арахиновая | 0.01 г | ~ | |||
| Мононенасыщенные жирные кислоты | 1.04 г | min 16.8 г | 6.2% | 5.7% | |
| 16:1 Пальмитолеиновая | 0.28 г | ~ | |||
| 18:1 Олеиновая (омега-9) | 0.72 г | ~ | |||
| 20:1 Гадолеиновая (омега-9) | 0.02 г | ~ | |||
| Полиненасыщенные жирные кислоты | 0.42 г | от 11.2 до 20.6 г | 3.8% | 3.5% | |
| 18:2 Линолевая | 0.31 г | ~ | |||
| 18:3 Линоленовая | 0.1 г | ~ | |||
| Омега-3 жирные кислоты | 0.1 г | от 0.9 до 3.7 г | 11.1% | 10.2% | |
| Омега-6 жирные кислоты | 0.31 г | от 4.7 до 16.8 г | 6.6% | 6.1% |
Энергетическая ценность Дрожжи составляет 109 кКал.
** В данной таблице указаны средние нормы витаминов и минералов для взрослого человека. Если вы хотите узнать нормы с учетом вашего пола, возраста и других факторов, тогда воспользуйтесь приложением «Мой здоровый рацион».
Вред дрожжей и противопоказания
Существует категория людей страдающих от аллергии или непереносимости на разные виды грибков, плесени. Для них опасны продукты, содержащих в составе пивные и пекарские дрожжи. Вред таким людям причиняют и дикие дрожжи, которые находятся на поверхности ягод и фруктов. Наносят пивные дрожжи вред, если человек страдает от:
- камней в почках;
- подагры;
- язвенного колита;
- болезни Крона;
- грибковых заболеваний (кандидоз).
Дрожжевые грибки активно взаимодействуют с некоторыми препаратами, что может нанести вред организму. Их нельзя принимать совместно со средствами от диабета, ингибиторами моноаминоксидазы (препараты от депрессии), димедролом. Есть и возрастные ограничения: дрожжевой продукт не рекомендован людям старше 70 лет.
Пивные дрожжи, польза и вред которых неоднозначны, помогают людям улучшить здоровье. Это факт, проверенный временем. Не стоит бояться вводить в рацион пищу, содержащую грибки. И тогда здоровье будет расти, как тесто на дрожжах.
Состав
Это живые одноклеточные мельчайшие организмы (грибы), которые растут по искусственным критериям. Большинство из них используются в производстве пива. Во время производства дрожжи начинают бродить, тем самым создавая специфический сладкий запах и вкус в напитке. В древние времена для приготовления такого вкусного и сладкого напитка использовались дикие дрожжи, но за короткое время датская пивоварня разработала искусственные пивные дрожжи, которые мы используем и сегодня.
В своем составе они содержат значительное количество витаминов и минералов. Особенно в этих условиях пивные дрожжи стали использовать в фармацевтических целях. Сегодня можно увидеть большее количество разнообразных видов или на биологическом уровне активных добавок с содержимым полок аптек.
Так почему же состав их настолько уникален:
- Более высокое содержание белка. Точнее говоря, он почти полностью всасывается в организм человека.
- Полный состав незаменимых аминокислот.
- Углеводы. Сто процентов целая группа витаминов В, Е, никотиновая кислота, Н, D, А.
- Омега-3, Омега-6, Омега-9.
- Ферменты
- Микро и макроэлементы — магний, кальций, фосфор, железо, селен, марганец и др.
Пивные дрожжи — одно из самых превосходных добавок, содержащее:
- 14 витаминов: группа B (обеспечивает нормальное функционирование центральной и периферической нервной системы, предотвращает появление болезни Паркинсона, ускоряет образование клеток, улучшает зрение, замедляет процесс старения), а также C, D, E, F, PP;
- 17 аминокислот, большинство из которых незаменимы; ненасыщенные жирные кислоты (арахидоновая кислота, олеиновая кислота и линолевая кислота);
- Калий, пирит, кальций, селен, фосфор, цинк, железо, натрий, сероватый, медь и другие микроэлементы.
- Все витамины, содержащиеся в пивных дрожжах, растворимы в воде и поэтому не накапливаются в организме. Эта добавка значительно улучшает здоровье при дефиците витаминов и гиповитаминозах.
- Пищевые добавки на основе пивных дрожжей полезны для повторения вегетарианцам: в состав таких продуктов входит фолиевая кислота, основным источником организма является мясная пища. Фолиевая кислота участвует в процессе синтеза ДНК при делении клеток и оказывает благотворное влияние на репродуктивную функцию.
Полезность пивных дрожжей заключается в следующем:
повысить аппетит, нормализовать пищеварение и обмен веществ;
- способствовать получению хорошего веса. Если масса тела слишком велика, из-за ускорения обменных процессов вы можете потерять лишние килограммы. Люди, не имеющие смысла, воспринимают дрожжи, наоборот, поправляются. Этот эффект часто используется спортсменами, которые хотят нарастить мышечную массу; из-за большего содержания пирита состояние пациентов с диабетом II типа упрощается;
- антиоксиданты замедляют процесс старения; предотвратить возникновение и развитие рака печени; успокаивать при стрессе, сенсорной усталости, резких перепадах настроения;
- восстановить силы при физической усталости, анемии, укрепить иммунитет;
- способствовать переносу значительных физических и умственных нагрузок; нормализуют работу сердечно-сосудистой системы;
- поддержание среднего уровня кислотно-щелочного баланса в организме;
- помочь избавиться от юношеских прыщей, высыпаний, укрепить состояние кожи при фурункулезе, дерматозах, экземах, псориазе; укрепляет волосы и останавливает их выпадение;
- укрепи свои ногти, сделай их наименее хрупкими.
В реализации есть три типа пивных дрожжей:
- Живые (водянистые) пивные дрожжи. Они продаются на пивоваренных заводах. Добавка в этой форме обладает огромной прочностью, но есть существенный недостаток: могут лежать при комнатной температуре не более 6-8 часов, а в холодильнике (при температуре от 7 до 10 ° С). Живые пивные дрожжи нельзя увидеть при грибковых заболеваниях (особенно при молочнице) и при дисбактериозе кишечника.
- Сухие в виде порошка или гранул продаются в аптеках, хранятся более длительный срок.
- В виде таблеток. В этой форме обычные пищевые добавки (активные добавки на биологическом уровне) производятся без примесей и обогащаются различными минералами или витаминами.

Определение и разновидности
Это одноклеточные грибы, а их видов сейчас насчитывается около 1000. Эти микроорганизмы имеют высокую способность выживания даже в самых неблагоприятных условиях вплоть до того, что они могут существовать и прекрасно себя чувствовать при полном отсутствии кислорода.
Грибы широко применяются как в медицине, так и в промышленности благодаря своей уникальной способности к быстро размножаться. Однако существуют виды, которые нельзя использовать ввиду их высокой способности вызывать различные заболевания у человека.
На сегодняшний день при изготовлении продуктов питания и на производствах используются четыре основных вида дрожжей:
- Пивные. Применяются в процессе приготовления сыра, напитков, медикаментозных препаратов.
- Молочные. Используются для сквашивания молока., незаменимы для изготовления кисломолочных продуктов.
- Винные. Хорошо заметны на спелых гроздьях винограда в виде белого налета. Вызывают процесс брожения фруктов.
- Хлебные (пекарские). Применяются при изготовлении ароматной выпечки, придают воздушность и объем готовому изделию.
Считается, что дрожжевые грибы имеют уникальный состав, поэтому они необходимы человеку.
Как принимать пивные дрожжи
К проблемам с лишним весом приводит неправильный обмен веществ, а пивные дрожжи, как раз, приводят его в норму. Их принимают как при ожирении, так и для набора веса. Они очищают кишечник, восстанавливают микрофлору. Но как самостоятельное средство для серьезного набора веса, или при похудании, его не выписывают, они просто помогают легче перенести эти процессы.
И все таки, если принимать дрожжи большими порциями, то мышечная масса значительно прибавится. Но, если будете придерживаться сбалансированного питания, Вас эта проблема не будет беспокоить.
Продукт принимают после еды. Покупайте их только в аптеке и четко следуйте инструкции. Курсы лечения пивными дрожжами должен назначать врач. Понаблюдайте за реакцией своего организма после того, как начнете их принимать. Если почувствуете такие симптомы, как отрыжка, понос или вздутие живота, прекратите прием. Если эти симптомы не исчезнут, обратитесь к своему врачу.
Будьте здоровы!
Сухие дрожжи
Сегодня найти в продаже живые дрожжи весьма проблематично. Большей популярностью пользуется сухой продукт, который продается в маленьких пакетиках. Высушенные грибки представляют собой небольшие гранулы округлой формы. Их срок годности может достигать двух лет. При этом все полезные свойства в них сохраняются. Для того чтобы они активизировались, их достаточно развести в теплой воде или молоке.Сухие дрожжи полезны при малокровии и в качестве средства для укрепления иммунной системы. В них содержится большое количество белка. Их не рекомендуется употреблять при подагре, дисбактериозе, а также острых болезнях желудочно-кишечного тракта.
Чистокровная верховная порода
Лошади этой породы самые резвые. Выведены они были в Англии в XVII-XVIII веках. В основе племенной работы лежал отбор наиболее резвых лошадей из числа арабской, варварийской, среднеазиатской пород. Решающее значение на выведение породы оказали стройная система тренинга и испытаний и строгий контроль за происхождением животных.
Для лошадей чистокровной верховой породы характерны крепкая, сухая конституция, прекрасно развитая, плотная мускулатура, длинные мощные конечности с ярко очерченными сухожилиями, тонкая кожа, под которой ясно виднеются сосуды. Эти лошади пылкого темперамента. Масти преимущественно гнедая и рыжая, реже вороная и серая. Многие полукровные породы в той или иной степени несут в себе кровь этой породы.
В России чистокровную верховую лошадь разводят уже более 200 лет. Животных выращивают на конных заводах и на ряде коневодческих ферм. Лучшим племенным хозяйством — в XX веке считался конный в Краснодарском крае, вырастивший серию великолепных скакунов. Наибольшую славу заводу принес гнедой жеребец Анилин (р. 1961), на котором известный жокей Н. Насибов трижды выиграл престижнейший приз Европы.
Лошадей чистокровной верховой породы разводят для племенных целей и для спорта.




























